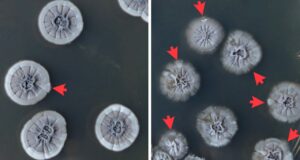
Vignette - Découverte scientifique sur la réparation de l'ADN de certaines bactéries du sol

Évènement
![Vignette - [Conférence] Les maladies des arbres](https://a2f.wp01.univ-lorraine.fr/wp-content/uploads/sites/39/2025/09/ecurey2-300x175.jpg)
06/06/2024 18:30
– 06/06/2024 20:00
[Conférence] Les maladies des arbres
Publié le 2024-05-22 10:00Évènement

25/05/2024 00:00
– 03/11/2024 00:00
Exposition Grand Nancy Terre de pollinisateurs
Publié le 2024-05-19 10:00Soutenance

Habilitation à Diriger des Recherches – PLAIN Caroline – SILVA
Publié le 2024-04-21 10:00Article

La végétation forestière en difficulté face au changement climatique
Publié le 2024-03-27 11:00Flash Talk

Plasticité phénotypique des espèces végétales le long d’un gradient environnemental en contexte de changement climatique
Amphi Gallé, site de Brabois
Publié le 2024-03-18 05:59Article
Découverte scientifique sur la réparation de l'ADN de certaines bactéries du sol
Publié le 2024-03-05 11:00Flash Talk

Inhibition de relaxases conjugatives de streptocoques pour limiter la diffusion des antibiorésistances
Amphi Gallé, site de Brabois
Publié le 2024-02-12 06:03Article
![Vignette - [Nos métiers, Nos portraits] Marion Triolet, ingénieure d'études au Laboratoire agronomie et environnement (LAE)](https://a2f.wp01.univ-lorraine.fr/wp-content/uploads/sites/39/2025/09/metier_portrait_v2bis-300x169.png)
Soutenance

Habilitation à Diriger des Recherches – SOLER Nicolas – DynAMic
Publié le 2024-01-24 11:00Évènement
![Vignette - [Entretiens Franco-Allemands de Nancy] Atelier grand public sur les apports des outils numériques dans l'étude de la biodiversité au LAE](https://a2f.wp01.univ-lorraine.fr/wp-content/uploads/sites/39/2025/09/efan-2024_1920x1080px-300x169.jpg)
09/02/2024 00:00
– 09/02/2024 00:00
[Entretiens Franco-Allemands de Nancy] Atelier grand public sur les apports des outils numériques dans l'étude de la biodiversité au LAE
Publié le 2024-01-16 11:00Article


![Logo-INRAE_Transparent-[Blanc]](https://a2f.wp01.univ-lorraine.fr/wp-content/uploads/sites/39/2023/07/logo-inrae_transparent-blanc.png)


![Vignette - [Théâtre] Des champs animés](https://a2f.wp01.univ-lorraine.fr/wp-content/uploads/sites/39/2025/09/theatre_impro_marion_ligier2_copie-300x226.png)